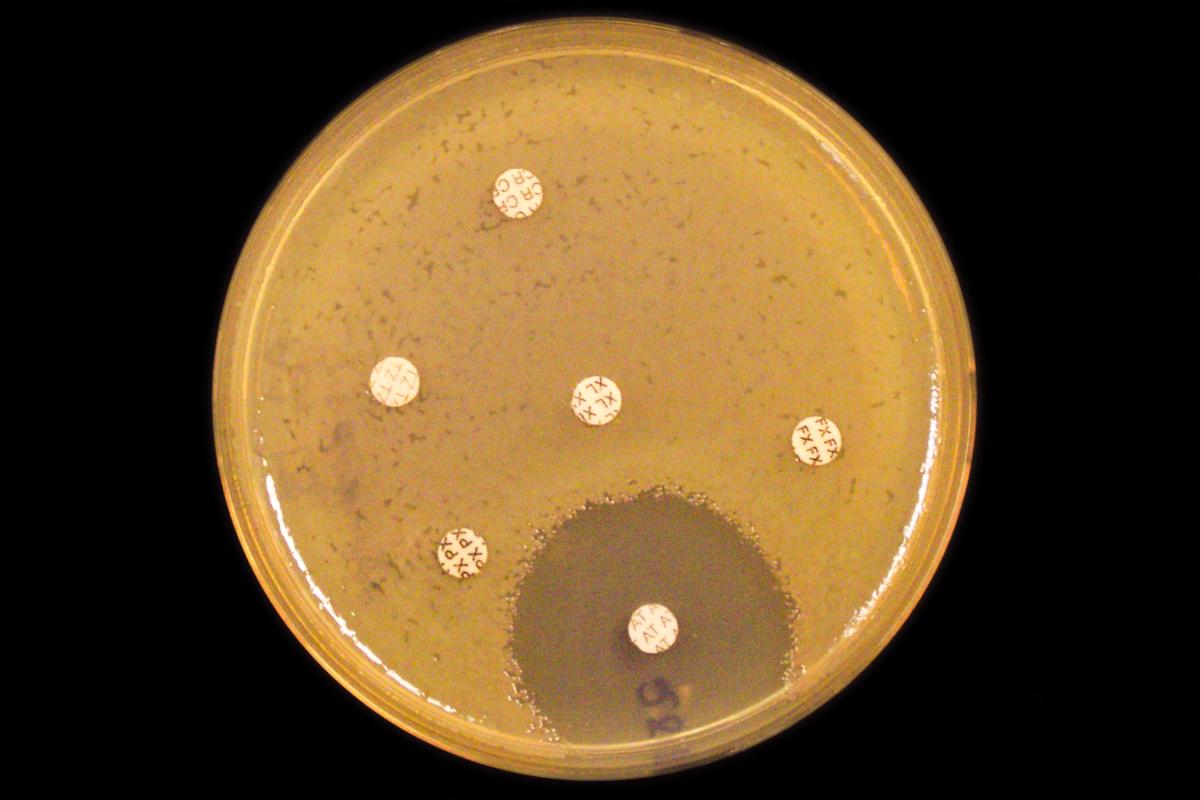
AMR BRIDGE_antibiotikaresistens_foto Nasjonalt senter for påvisning av antibiotikaresistens K-res.jpg

Seks viktige grep i kampen mot antibiotikaresistens (dagensmedisin.no)
Vi kan lykkes, men det krever modige grep fra helsemyndighetene og private finansieringskilder.
Antimikrobiell resistens (AMR) er en av de største truslene mot den globale folkehelsen. En studie som nylig ble publisert i The Lancet viser at vi i 2050 - om bare 25 år - vil ha 10 millioner dødsfall årlig som en direkte eller indirekte konsekvens av AMR.
Les også kronikken i Dagens Medisin (publisert 12. mars 2025)
Til sammenligning er det offisielle antall registrerte dødsfall direkte knyttet til COVID-19 pandemien syv millioner globalt, ifølge Verdens helseorganisasjon.
Etter flere års arbeid i forskningsnettverket AMR BRIDGE ved NTNU, Universitetet i Oslo, Helse Bergen/Universitetet i Bergen og UiT Norges arktiske universitet, foreslår vi nå seks tiltak som kan bli livsviktige i kampen mot antibiotikaresistente bakterier.
Last ned kunnskapsdokumentet "Seks viktige steg for å bekjempe antimikrobiell resistens" (AMR)
Utvikle hurtigdiagnostikk
Presis diagnostikk av en infeksjon er avgjørende for å kunne bruke antibiotika riktig. Siden alvorlige infeksjoner ofte har et stormende forløp, er det nødvendig å utvikle nye metoder som gir raske svar. Vår studie av hurtigdiagnostikk ved mistanke om lungebetennelse viser at slike metoder er både raske og pålitelige.
Hurtigdiagnostikk setter legen i stand til å foreta raske beslutninger. Dermed kan pasientene raskere få riktig behandling, og antibiotikabruken vil kunne snevres inn. Da vil også risikoen for utvikling av antibiotikaresistens bli redusert.
Nye antibiotika og nye behandlingsstrategier
Fordi bakteriene hele tiden muterer og tilpasser seg nye utfordringer, er utvikling av resistens uunngåelig, Derfor vil vi alltid trenge påfyll av nyutviklede antibiotika som virker på nye måter.
Vi må også utvikle og ta i bruk alternative og komplementære strategier i forebygging og behandling av bakterieinfeksjoner. Dette inkluderer bruk av bakteriofager, som kan infisere og drepe uønskede bakterier.
Bidra til nye insentiver
Det tar lang tid og er veldig kostbart å utvikle nye antibiotika. De siste 30 årene har dette ikke vært lønnsomt, og for få nye medisiner er blitt utviklet til å møte de store utfordringene vi allerede har.
Myndighetene i USA, EU og UK arbeider sammen med farmasøytisk industri for å etablere insentiver slik at man ikke – som i dag – taper penger på å utvikle nye antibiotika. Dersom stater forplikter seg til å kjøpe en viss mengde av nye, godkjente antibiotika, sikrer vi lønnsomhet for de som utvikler nye antibiotika.
Norge bør oppmuntre til, og slutte seg til disse ordningene. Gjør vi det vil vi støtte utvikling av nye antibiotika, og få tilgang til nye antibiotika på samme tid som de andre deltakerlandene.
Offentlig-privat samfinansiering
Norges forskningsråd (NFR) spiller en nøkkelrolle i offentlig finansiering av grunnforskning. NFR bør også kunne koordinere en felles innsats fra det offentlige og fra norske private stiftelser.
Vi ser for oss et felles norsk finansieringsprogram som samler både private stiftelser og NFR. Det vil være et nødvendig norsk bidrag til å styrke grunnforskningen og fremme utvikling av ny banebrytende kunnskap som er essensiell for mere langsiktig løsninger på utfordringene.
Forskning på globale helseutfordringer
Effektene av AMR og infeksjoner forårsaket av resistente bakterier påvirker innbyggerne i lav- og mellominntektsland langt sterkere enn oss som lever i rike land.
NFR har vært aktiv i å finansiere helseforskning i lav- og mellominntektsland, men denne innsatsen har hittil ikke vært rettet inn mot AMR. Forskning på antibiotikaresistens i en global setting vil gi en gylden mulighet til å forbedre global helse der det trengs aller mest.
Bakterieovervåking hos mennesker, dyr og i miljøet
I 25 år har Norge hatt et av verdens mest omfattende overvåkingssystemene for antibiotikaresistens hos mennesker (NORM) og dyr, fôr og næringsmidler (NORM-VET). Men NORM fanger bare opp de bakterievariantene som dukker opp i prøver fra syke pasienter.
For å kunne forsterke sporing og kartlegge spredningen av resistente og sykdomsfremkallende bakterier er det nødvendig med en bredere men målrettet overvåking av bakteriefloraen i samfunnet, inkludert miljøet og bærerskap hos friske personer. Dette kan gi grunnlag for spesifikke forebyggende tiltak.
Norge har igjen en mulighet til å være pionér på dette feltet, på samme måte som da NORM og NORM-VET systemet ble etablert.
Vi må handle nå
Nå er det opp til norske helsemyndigheter og finansieringskilder å følge opp med konkrete tiltak i forlengelsen av den nye nasjonale strategien mot antibiotikaresistens. Uten rask handling vil de resistente bakteriene kunne få større fotfeste og true moderne medisinsk behandling, også her i Norge.
Jukka Corander, professor ved Universitetet i Oslo
Marit Otterlei, professor ved NTNU
Arnfinn Sundsfjord, professor ved UiT Norges arktiske universitet
Elling Ulvestad, professor ved Universitetet i Bergen og overlege i Helse Bergen
Nasjonalt forskningsprogram på antibiotikaresistens (AMR)
Forskningsprosjektene i AMR BRIDGE har vært finansiert gjennom Trond Mohn forskningsstiftelse og deres Nasjonalt forskningsprogram på antibiotikaresistens (AMR).
Antimikrobiell resistens (AMR)
Betegnelsen AMR brukes for å beskrive bakterier, virus, sopp og parasitter som har utviklet motstandsdyktighet mot antimikrobielle midler. AMR er en naturlig forsvarsmekanisme som mikrobene videreutvikler i møte med antibiotika. De viktigste driverne for utviklingen av AMR er overforbruk og feilbruk av antimikrobielle midler.
https://www.who.int/news-room/fact-sheets/detail/antimicrobial-resistance
Publisert: 12.03.2025
Lenke til denne siden